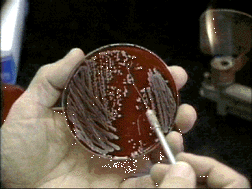

| Suckers: How Alternative Medicine Makes Fools of Us All
by Rose Shapiro
Suckers reveals how alternative medicine can jeopardize the health of those it claims to treat, leaches resources from treatments of proven efficacy and is largely unaccountable and unregulated. In short, it is an industry that preys on human vulnerability and makes fools of us all. |
| The Cure Within A History of Mind-Body Medicine
by Anne Harrington
Reviewed by Dr. Jerome Groopman
In The Cure Within, her splendid history of mind-body medicine, Anne Harrington tries to explain why we draw connections between emotions and illness, and helps trace how todays myriad alternative and complementary treatments came to be. A professor and chairman of the history of science department at Harvard, Harrington has produced a book that desperately needed to be written. |

|
|
 Meningitis Research Foundation of CanadaA mother's efforts in memory of her son who died in 1995 For more information, phone and fax 519-746-8306 or 1-800-643-1303
The mailing address is Box 28015 R.P.O. Parkdale, Waterloo, N2L 6J8.
|
Foundations for Meningitis research in the U.S.
|